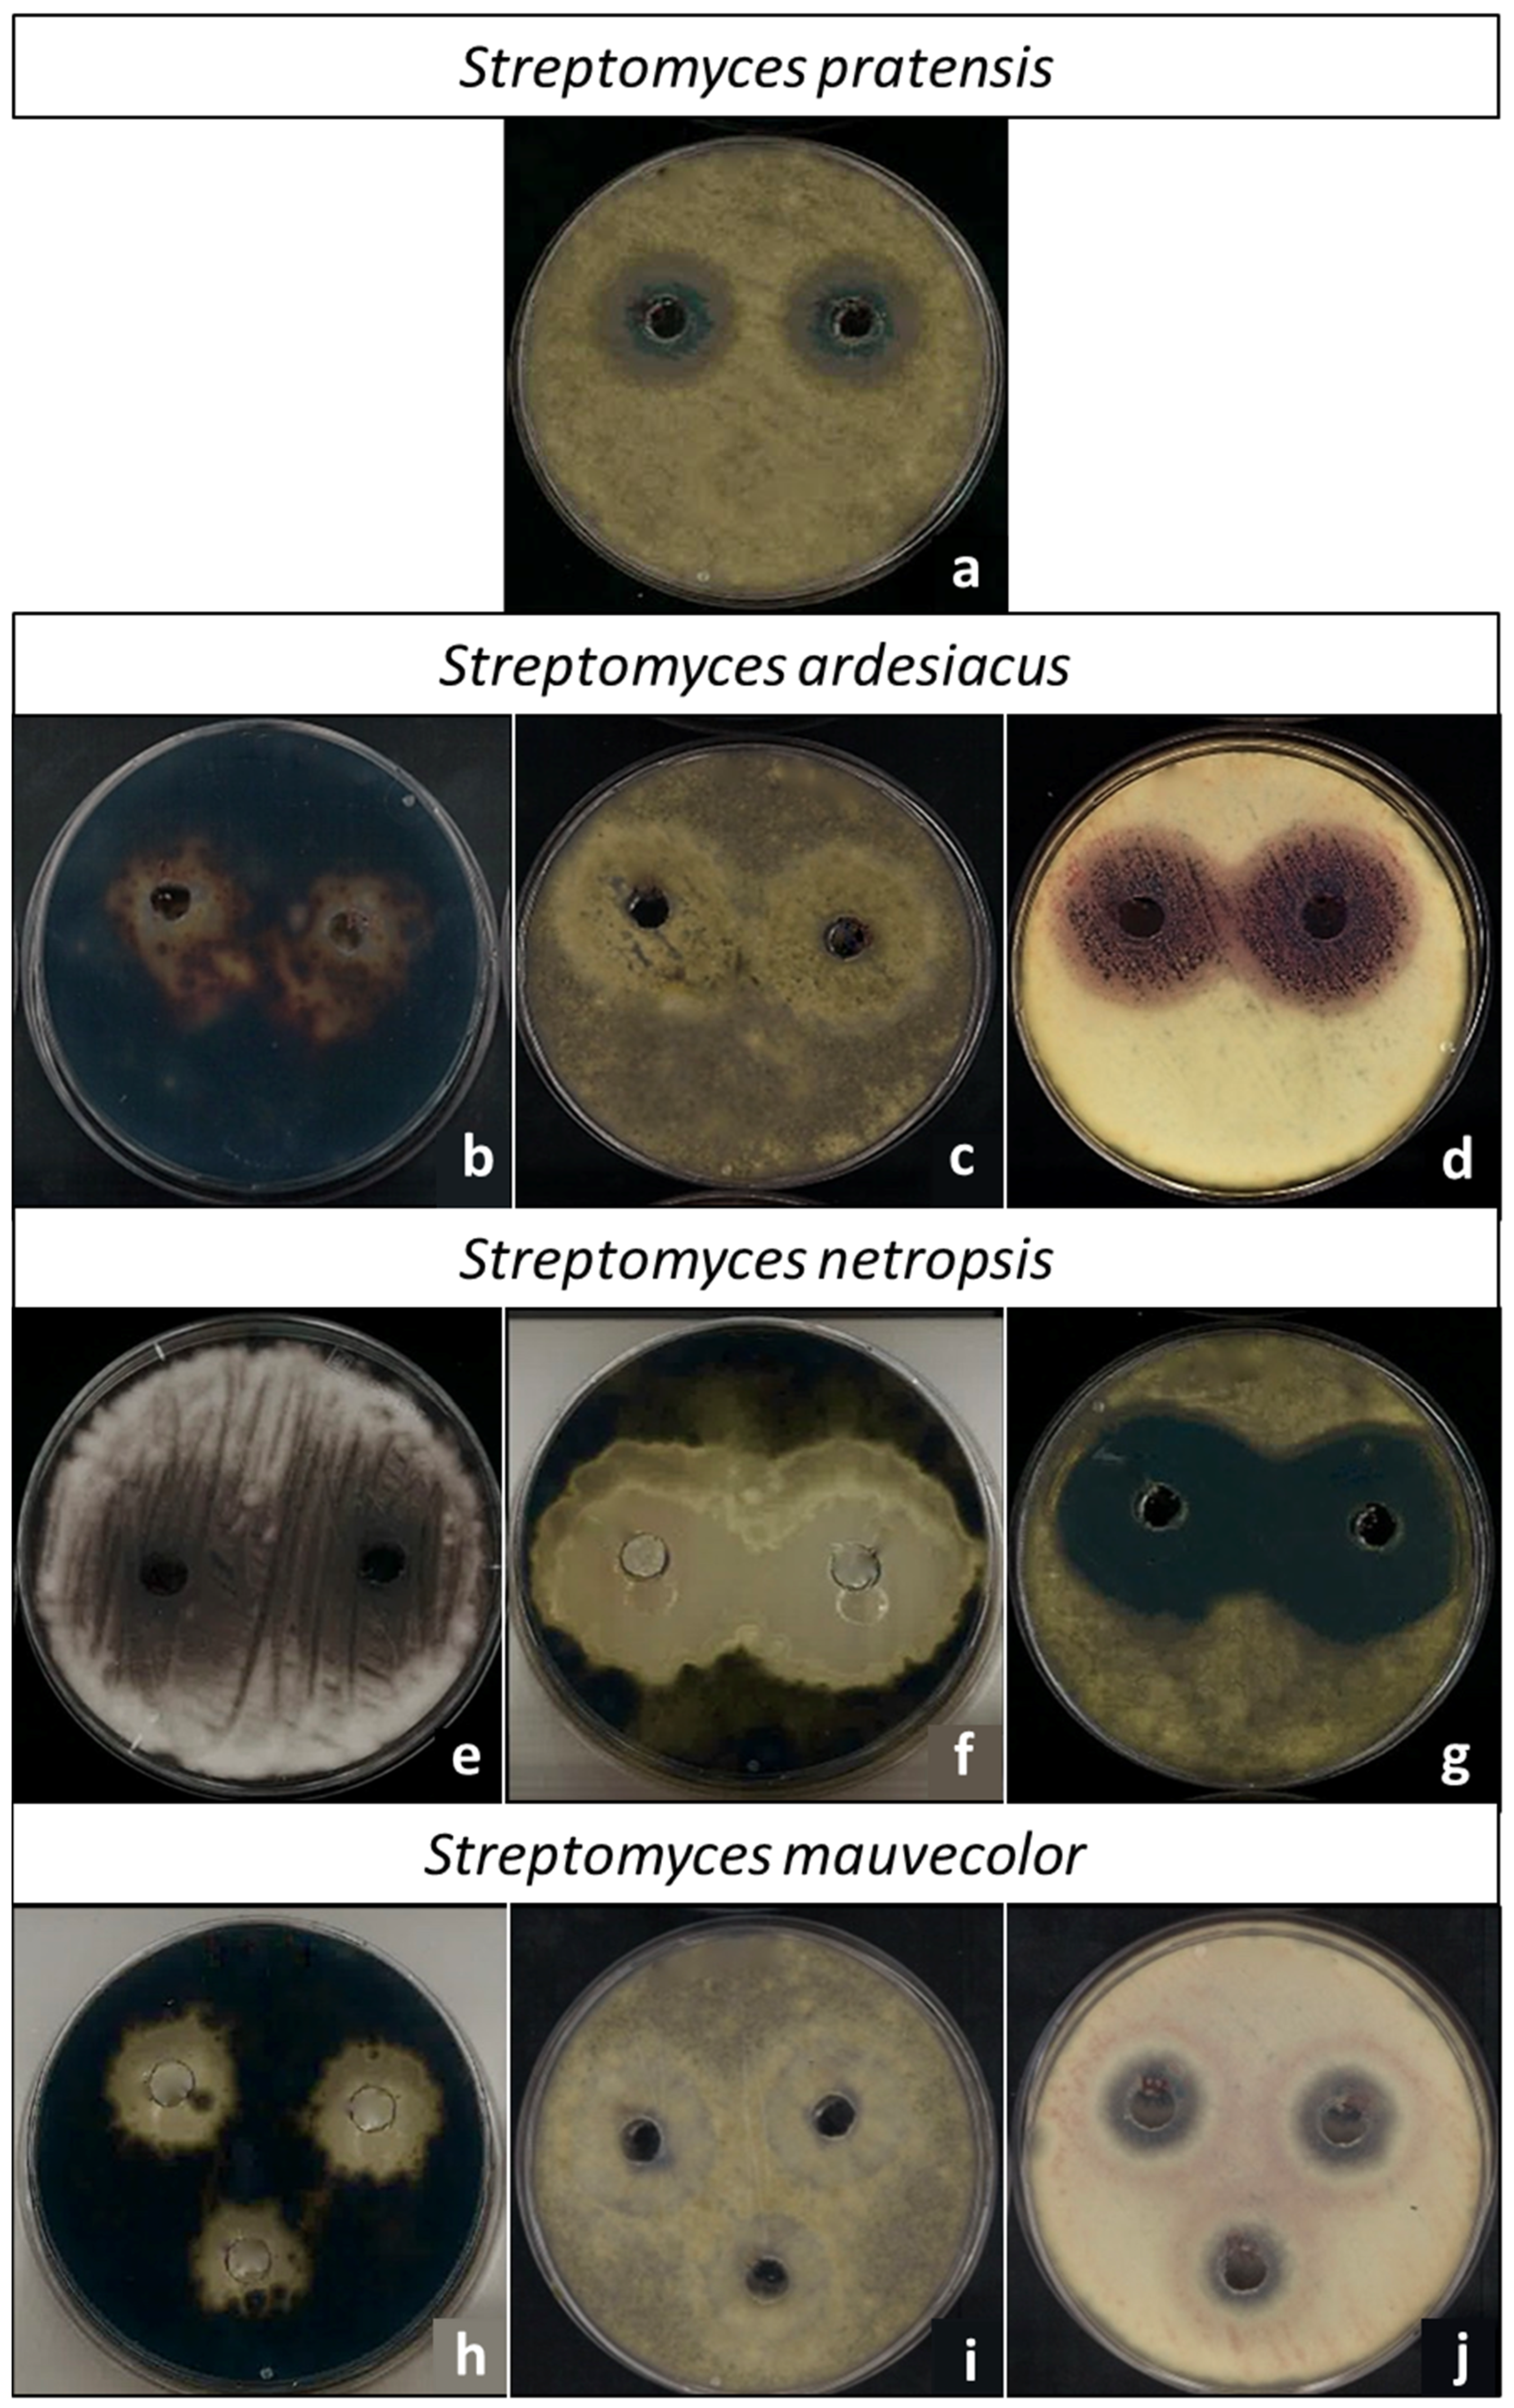
Horticulturae 09 01319 g003

Antifungal Activity of Streptomyces spp. Extracts In Vitro and on Post-Harvest Tomato Fruits against Plant Pathogenic Fungi
Abstract
:1. Introduction
2. Materials and Methods
2.1. Strains, Culture Growth and Co-Cultures
2.2. Antifungal Activity of the Media
2.3. Media Solvent Extraction and Concentration
2.4. Extract Antifungal Activity on Post-Harvest Cherry Tomatoes
2.5. Statistical Analysis
3. Results
3.1. Actinomycetes Co-Culture Growth Inhibition and Antifungal Activity In Vitro
3.2. Actinomycetes Species Antifungal Activity In Vitro
3.3. Organic Solvent Extraction and Antifungal Activity
3.4. Botrytis Growth Inhibition on Cherry Tomatoes
4. Discussion
5. Conclusions
Author Contributions
Funding
Data Availability Statement
Acknowledgments
Conflicts of Interest
References
- Bahadur, I. The novel potassic bio-fertilizers: A promising approach for evergreen agriculture. Int. J. Microbiol. Res. 2015, 7, 692–697. [Google Scholar]
- Bahadur, I.; Maurya, R.; Roy, P.; Kumar, A. Potassium-solubilizing bacteria (KSB): A microbial tool for K-solubility, cycling, and availability to plants. In Plant Growth Promoting Rhizobacteria for Agricultural Sustainability: From Theory to Practices; Kumar, A., Meena, V., Eds.; Springer: Singapore, 2019; pp. 257–265. [Google Scholar]
- Bandara, A.Y.; Weerasooriya, D.K.; Bradley, C.A.; Allen, T.W.; Esker, P.D. Dissecting the economic impact of soybean diseases in the United States over two decades. PLoS ONE 2020, 15, e0231141. [Google Scholar] [CrossRef] [PubMed]
- Fernandez-San Millan, A.; Larraya, L.; Farran, I.; Ancin, M.; Veramendi, J. Successful biocontrol of major postharvest and soil-borne plant pathogenic fungi by antagonistic yeasts. Biol. Control 2021, 160, 104683. [Google Scholar] [CrossRef]
- Parra-Amin, J.E.; Cuca, L.E.; González-Coloma, A. Antifungal and phytotoxic activity of benzoic acid derivatives from inflorescences of Piper cumanense. Nat. Prod. Res. 2021, 35, 2763–2771. [Google Scholar] [CrossRef] [PubMed]
- Mederos-Torres, Y.; Bernabé-Galloway, P.; Ramírez-Arrebato, M.A. Películas basadas en polisacáridos como recubrimientos biodegradables y su empleo en la postcosecha de los frutos. Cultiv. Trop. 2020, 41, e09. [Google Scholar]
- Truchado, P.; Allende, A. La implicación de las frutas y hortalizas en las toxiinfecciones alimentarias y la relevancia del estado fisiológico de las bacterias. Arbor 2020, 196, a541. [Google Scholar] [CrossRef]
- Salwan, R.; Sharma, V. Bioactive compounds of Streptomyces: Biosynthesis to applications. Stud. Nat. Prod. Chem. 2020, 64, 467–491. [Google Scholar]
- Hernández-Bolaños, E.; Montesdeoca-Flores, D.T.; Abreu-Yanes, E.; Barrios, M.; Abreu-Acosta, N. Evaluating different methodologies for bioprospecting actinomycetes in Canary Islands soils. Curr. Microbiol. 2020, 77, 2510–2522. [Google Scholar] [CrossRef] [PubMed]
- Abd-Alla, M.H.; Rasmey, A.H.M.; El-Sayed, E.S.A.; El-Kady, I.A.; Yassin, I.M. Biosynthesis of anti-inflammatory immunosuppressive metabolite by Streptomyces variabilis ASU319. Eur. J. Biol. Res. 2016, 6, 152–169. [Google Scholar]
- Bentley, S.D.; Chater, K.F.; Cerdeño-Tárraga, A.M.; Challis, G.L.; Thomson, N.R.; James, K.D.; Harris, D.E.; Quail, M.A.; Kieser, H.; Harper, D.; et al. Complete genome sequence of the model actinomycete Streptomyces coelicolor A3 (2). Nature 2002, 417, 141–147. [Google Scholar] [CrossRef] [PubMed]
- Ōmura, S.; Ikeda, H.; Ishikawa, J.; Hanamoto, A.; Takahashi, C.; Shinose, M.; Takahashi, Y.; Horikawa, H.; Nakazawa, H.; Osonoe, T.; et al. Genome sequence of an industrial microorganism Streptomyces avermitilis: Deducing the ability of producing secondary metabolites. Proc. Natl. Acad. Sci. USA 2001, 98, 12215–12220. [Google Scholar] [CrossRef] [PubMed]
- Pérez, J.; Muñoz-Dorado, J.; Braña, A.F.; Shimkets, L.J.; Sevillano, L.; Santamaría, R.I. Myxococcus xanthus induces actinorhodin overproduction and aerial mycelium formation by Streptomyces coelicolor. Microb. Biotechnol. 2011, 4, 175–183. [Google Scholar] [CrossRef]
- Lee, N.; Kim, W.; Chung, J.; Lee, Y.; Cho, S.; Jang, K.S.; Kim, S.C.; Palsson, B.; Cho, B.K. Iron competition triggers antibiotic biosynthesis in Streptomyces coelicolor during coculture with Myxococcus xanthus. ISME J. 2020, 14, 1111–1124. [Google Scholar] [CrossRef] [PubMed]
- Chen, H.; Xiao, X.; Wang, J.; Wu, L.; Zheng, Z.; Yu, Z. Antagonistic effects of volatiles generated by Bacillus subtilis on spore germination and hyphal growth of the plant pathogen, Botrytis cinerea. Biotechnol. Lett. 2008, 30, 919–923. [Google Scholar] [CrossRef] [PubMed]
- Boorn, K.L.; Khor, Y.Y.; Sweetman, E.; Tan, F.; Heard, T.A.; Hammer, K.A. Antimicrobial activity of honey from the stingless bee Trigona carbonaria determined by agar diffusion, agar dilution, broth microdilution and time-kill methodology. J. Appl. Microbiol. 2010, 108, 1534–1543. [Google Scholar] [CrossRef] [PubMed]
- Esteban, A.; Abarca, M.L.; Cabañes, F.J. Comparison of disk diffusion method and broth microdilution method for antifungal susceptibility testing of dermatophytes. Med. Mycol. 2005, 43, 61–66. [Google Scholar] [CrossRef] [PubMed]
- Garmendia, G.; Vero, S. Métodos para la desinfección de frutas y hortalizas. Horticultura 2006, 197, 18–27. [Google Scholar]
- Abdelmoteleb, A.; González-Mendoza, D. A novel Streptomyces rhizobacteria from desert soil with diverse anti-fungal properties. Rhizosphere 2020, 16, 100243. [Google Scholar] [CrossRef]
- Watve, M.G.; Tickoo, R.; Jog, M.M.; Bhole, B.D. How many antibiotics are produced by the genus Streptomyces? Arch. Microbiol. 2001, 176, 386–390. [Google Scholar] [CrossRef] [PubMed]
- Driche, E.H.; Belghit, S.; Bijani, C.; Zitouni, A.; Sabaou, N.; Mathieu, F.; Badji, B. A new Streptomyces strain isolated from Saharan soil produces di-(2-ethylhexyl) phthalate, a metabolite active against methicillin-resistant Staphylococcus aureus. Ann. Microbiol. 2015, 65, 1341–1350. [Google Scholar] [CrossRef]
- Prapagdee, B.; Kuekulvong, C.; Mongkolsuk, S. Antifungal potential of extracellular metabolites produced by Streptomyces hygroscopicus against phytopathogenic fungi. Int. J. Biol. Sci. 2008, 4, 330. [Google Scholar] [CrossRef] [PubMed]
- Anitha, A.; Rebeeth, M. In vitro antifungal activity of Streptomyces griseus against phytopathogenic fungi of tomato field. Acad. J. Plant Sci. 2009, 2, 119–123. [Google Scholar]
- Cai, L.; Zhang, H.; Deng, Y.; Tian, W.; Fan, G.; Sun, X. Antifungal Activity of Streptomyces hygroscopicus JY-22 against Alternaria alternata and Its Potential Application as a Biopesticide to Control Tobacco Brown Spot. Agronomy 2023, 13, 1944. [Google Scholar] [CrossRef]
- Wang, Y.; Yang, D.; Yu, Z. New Lactones Produced by Streptomyces sp. SN5431 and Their Antifungal Activity against Bipolaris maydis. Microorganisms 2023, 11, 616. [Google Scholar] [CrossRef] [PubMed]
- Santamaría, R.I.; Martínez-Carrasco, A.; Tormo, J.R.; Martín, J.; Genilloud, O.; Reyes, F.; Díaz, M. Interactions of Different Streptomyces Species and Myxococcus xanthus Affect Myxococcus Development and Induce the Production of DK-Xanthenes. Int. J. Mol. Sci. 2023, 24, 15659. [Google Scholar] [CrossRef] [PubMed]
- Afroz-Toma, M.; Rahman, M.H.; Rahman, M.S.; Arif, M.; Nazir, K.N.H.; Dufossé, L. Fungal Pigments: Carotenoids, Riboflavin, and Polyketides with Diverse Applications. J. Fungi 2023, 9, 454. [Google Scholar] [CrossRef] [PubMed]
- Dean, R.; Van Kan, J.A.; Pretorius, Z.A.; Hammond-Kosack, K.E.; Di Pietro, A.; Spanu, P.D.; Rudd, J.J.; Dickman, M.; Kahmann, R.; Ellis, J.; et al. The Top 10 fungal pathogens in molecular plant pathology. Mol. Plant Pathol. 2012, 13, 414–430. [Google Scholar] [CrossRef]
- Tsalidis, G.A. Human health and ecosystem quality benefits with life cycle assessment due to fungicides elimination in agriculture. Sustainability 2022, 14, 846. [Google Scholar] [CrossRef]
- Chacon-Lopez, A.; Guardado-Valdivia, L.; Banuelos-Gonzalez, M.; Lopez-Garcia, U.; Montalvo-González, E.; Arvizu-Gomez, J.; Arvizu-Gómez, J.; Stoll, A.; Aguilera, S. Effect of metabolites produced by Bacillus atrophaeus and Brevibacterium frigoritolerans strains on postharvest biocontrol of Alternaria alternata in tomato (Solanum lycopersicum L.). Biocontrol Sci. 2021, 26, 67–74. [Google Scholar] [CrossRef]
- Chaouachi, M.; Marzouk, T.; Jallouli, S.; Elkahoui, S.; Gentzbittel, L.; Ben, C.; Djébali, N. Activity assessment of tomato endophytic bacteria bioactive compounds for the postharvest biocontrol of Botrytis cinerea. Postharvest Biol. Technol. 2021, 172, 111389. [Google Scholar] [CrossRef]
- Zhu, L.; Ni, W.; Liu, S.; Cai, B.; Xing, H.; Wang, S. Transcriptomics analysis of apple leaves in response to Alternaria alternata apple pathotype infection. Front. Plant Sci. 2017, 8, 22. [Google Scholar] [CrossRef] [PubMed]
- Muñoz-Carpena, R.; Ritter, A.; Socorro, A.R.; Perez, N. Nitrogen evolution and fate in a Canary Islands (Spain) sprinkler fertigated banana plot. Agric. Water Manag. 2002, 52, 93–117. [Google Scholar] [CrossRef]
- De Cossío, Á.G. Nueva ayuda al sector de producción de plátanos de Canarias. Hacienda Canar. 2008, 2008, 129–152. [Google Scholar]
- Costa, J.M.; Heuvelink, E.P. The global tomato industry. In Tomatoes; Heuvelink, E.P., Ed.; CABI: Wallingford, UK, 2018; pp. 1–26. [Google Scholar]

Disclaimer/Publisher’s Note: The statements, opinions and data contained in all publications are solely those of the individual author(s) and contributor(s) and not of MDPI and/or the editor(s). MDPI and/or the editor(s) disclaim responsibility for any injury to people or property resulting from any ideas, methods, instructions or products referred to in the content. |
© 2023 by the authors. Licensee MDPI, Basel, Switzerland. This article is an open access article distributed under the terms and conditions of the Creative Commons Attribution (CC BY) license (https://creativecommons.org/licenses/by/4.0/).
Share and Cite
Montesdeoca-Flores, D.T.; Hernández-Bolaños, E.; León-Barrios, M.; Hernández-Amador, E.; Díaz-González, S.; Abreu-Acosta, N.; Luis-Jorge, J.C. Antifungal Activity of Streptomyces spp. Extracts In Vitro and on Post-Harvest Tomato Fruits against Plant Pathogenic Fungi. Horticulturae 2023, 9, 1319. https://doi.org/10.3390/horticulturae9121319
Montesdeoca-Flores DT, Hernández-Bolaños E, León-Barrios M, Hernández-Amador E, Díaz-González S, Abreu-Acosta N, Luis-Jorge JC. Antifungal Activity of Streptomyces spp. Extracts In Vitro and on Post-Harvest Tomato Fruits against Plant Pathogenic Fungi. Horticulturae. 2023; 9(12):1319. https://doi.org/10.3390/horticulturae9121319
Chicago/Turabian StyleMontesdeoca-Flores, David Tomás, Eduardo Hernández-Bolaños, Milagros León-Barrios, Eduardo Hernández-Amador, Selene Díaz-González, Néstor Abreu-Acosta, and Juan Cristo Luis-Jorge. 2023. "Antifungal Activity of Streptomyces spp. Extracts In Vitro and on Post-Harvest Tomato Fruits against Plant Pathogenic Fungi" Horticulturae 9, no. 12: 1319. https://doi.org/10.3390/horticulturae9121319
APA StyleMontesdeoca-Flores, D. T., Hernández-Bolaños, E., León-Barrios, M., Hernández-Amador, E., Díaz-González, S., Abreu-Acosta, N., & Luis-Jorge, J. C. (2023). Antifungal Activity of Streptomyces spp. Extracts In Vitro and on Post-Harvest Tomato Fruits against Plant Pathogenic Fungi. Horticulturae, 9(12), 1319. https://doi.org/10.3390/horticulturae9121319

